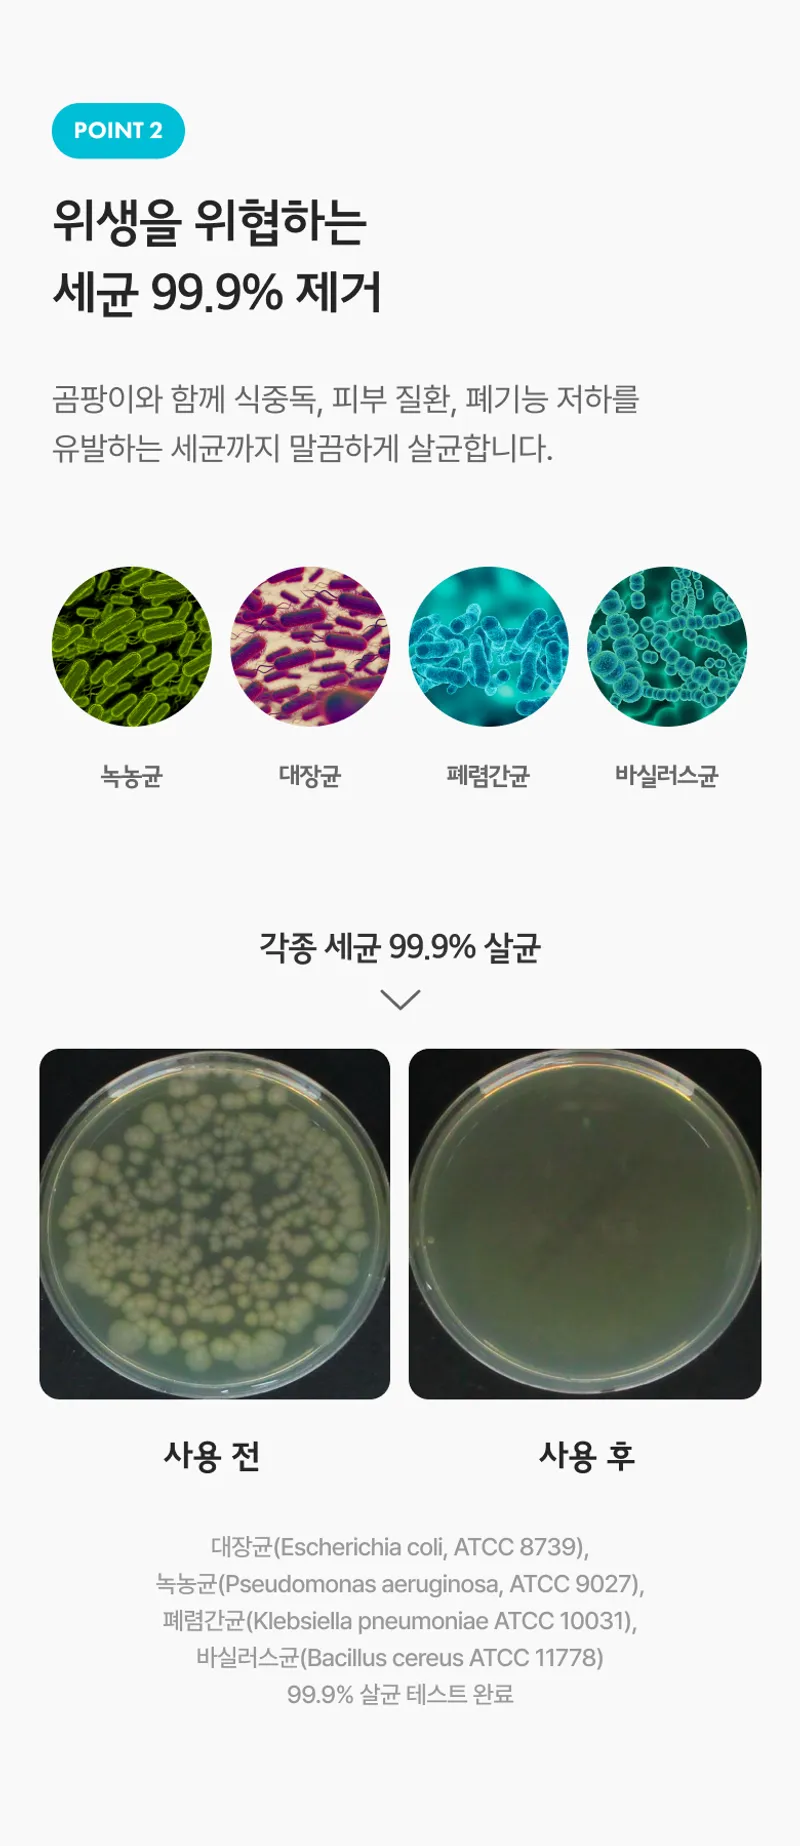

최대 10,000원 할인 받으세요!
팔도감은 모든 상품 무료배송
간편하게 뿌리는 곰팡이 제거제 (거품 타입) 400ml
165개 후기 보기
31%
15,900원
10,900원
배송정보
무료배송
CJ대한통운
후기 165개
전체보기
평점 4.8
로 고객 만족도가 높은 상품입니다
옵션: [1+1] 곰팡이 제거제(거품 타입) 400ml*1개

2
옵션: 곰팡이 제거제(거품 타입) 400ml*2개

2
옵션: 곰팡이 제거제(거품 타입) 400ml*2개

옵션: 곰팡이 제거제(거품 타입) 400ml*1개

옵션: 곰팡이 제거제(거품 타입) 400ml*2개

팔도감 베스트 상품
상품 설명

배송 / 교환 / 반품 안내
채팅 문의하기
상품/배송/기타 궁금하신 내용을 문의하세요
당신을 위한 추천
찜
선물하기

